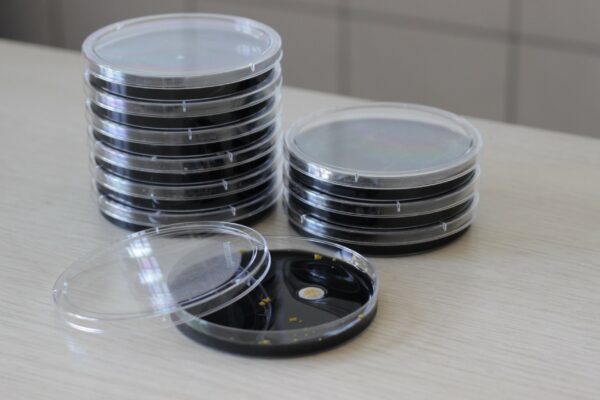

Klare Analyse.
Klares Wasser.
Die Team Umweltanalytik GmbH ist ein akkreditiertes Prüflaboratorium mit langjährigen Erfahrungen in Probenahme und Analytik. Schwerpunkt unserer Arbeit sind Wasseruntersuchungen.
Unsere Motivation ist es, Sie durch Kompetenz, Flexibilität, Schnelligkeit und Fairness zu überzeugen.
Unabhängig davon, in welchem Bereich Sie tätig sind: Wir sind Ihr kompetenter Ansprechpartner in Fragen der Untersuchung von Wasser, Trinkwasser und von Materialien, die mit Wasser in Berührung kommen. Von der Beratung und Ermittlung des Untersuchungsbedarfs über die Probenahme und Analytik durch unser akkreditiertes Prüflabor bis hin zur Beurteilung der Ergebnisse und Hilfe bei wasserhygienischen Fragen sind wir gern Ihr Partner.